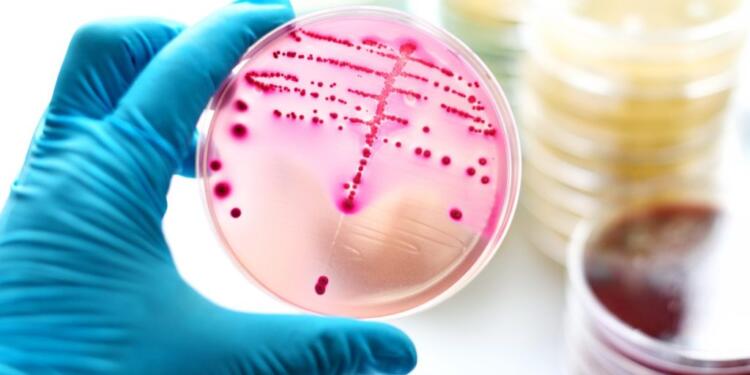

Λόγω της έξαρσης των στρεπτοκοκκικών λοιμώξεων το CDC εξέδωσε οδηγίες που αφορούν την μετάδοση, τα συμπτώματα και τις επιπλοκές του στρεπτόκοκκου.
Ο στρεπτόκοκκος ομάδας Α, γνωστός και ως πυογόνος στρεπτόκοκκος, είναι ένα βακτήριο που μπορεί να προκαλέσει διάφορες λοιμώξεις στον άνθρωπο από ηπιότερες έως και σπανιότερα πιο σοβαρές. Αν και συχνότερα ο πονόλαιμος προκαλείται από ιούς, μια λοίμωξη στον φάρυγγα και τις αμυγδαλές μπορεί επίσης να οφείλεται στο βακτήριο του στρεπτόκοκκου ομάδας Α.
Οι ιατροί της Θεραπευτικής Κλινικής (Νοσοκομείο Αλεξάνδρα) Παθολόγος Καθηγήτρια Επιδημιολογίας και Προληπτικής Ιατρικής Θεοδώρα Ψαλτοπούλου και η Βιολόγος Παναγιώτα Ζαχαράκη περιληπτικά παραθέτουν τις πρόσφατες οδηγίες του CDC.
Πώς μεταδίδεται ο στρεπτόκοκκος ομάδας Α
Ο στρεπτόκοκκος ομάδας Α είναι πολύ μεταδοτικός. Γενικά, οι άνθρωποι μεταδίδουν τα βακτήρια σε άλλους είτε μέσω αναπνευστικών σταγονιδίων είτε με απευθείας επαφή. Ο στρεπτόκοκκος της ομάδας Α μπορεί να μεταδοθεί ακόμη και μέσω τροφίμων. Συνήθως χρειάζονται 2 έως 5 ημέρες μετά την έκθεση, για τη νόσηση από στρεπτόκοκκο ομάδας Α. Ο στρεπτόκοκκος τύπου Α μεταδίδεται μιλώντας, βήχοντας ή φτερνίζοντας.
Η νόσηση μπορεί να προκύψει εάν οι άνθρωποι:
- Εισπνεύσουν σταγονίδια του αναπνευστικού που περιέχουν τα βακτήρια.
- Αγγίξουν το στόμα ή τη μύτη τους αφού αγγίξουν κάτι επιμολυσμένο.
- Χρησιμοποιήσουν το ίδιο πιάτο, σκεύος ή ποτήρι με ένα μολυσμένο άτομο.
- Απευθείας επαφή
Οι άνθρωποι μπορούν επίσης να μεταδόσουν βακτήρια στρεπτόκοκκου της ομάδας Α από μολυσμένες πληγές στο δέρμα. Έτσι, μπορούν να μολύνουν κάποιο άλλο άτομο, εάν αυτό αγγίξει αυτές τις πληγές ή έρθει σε επαφή με υγρό από τις πληγές.
Οι άνθρωποι είναι μεταδοτικοί ακόμα και χωρίς συμπτώματα. (ασυμπτωματικοί φορείς)
Μερικοί άνθρωποι που έχουν μολυνθεί από στρεπτόκοκκο της ομάδας Α δεν έχουν συμπτώματα, ούτε και φαίνονται άρρωστοι. Οι άνθρωποι που νοσούν από στρεπτόκοκκο είναι πιο μεταδοτικοί από τους ασυμπτωματικούς φορείς.
Ποια είναι τα συμπτώματα
Στα περισσότερο συχνά συμπτώματα περιλαμβάνονται ο πόνος και ο πυρετός. Γενικά, ο στρεπτόκοκκος είναι μια ήπια ασθένεια, αλλά μπορεί να είναι πολύ επώδυνη.
Αναλυτικότερα στα κοινά συμπτώματα περιλαμβάνονται:
- Πυρετός
- Πόνος κατά την κατάποση
- Πονόλαιμος που ξεκίνησε πολύ γρήγορα και ερυθρός λαιμός
- Ερυθρές και πρησμένες αμυγδαλές
- Διόγκωση των αμυγδαλών με λευκωπό επίχρισμα
- Αιμορραγικά στίγματα στην υπερώα (πετέχειες)
- Διόγκωση λεμφαδένων στο μπροστινό μέρος του λαιμού
Στα λιγότερο συχνά συμπτώματα μπορεί να περιλαμβάνονται ο έμετος και ο πονοκέφαλος.
Μερικοί άνθρωποι, ειδικά τα παιδιά, μπορεί να έχουν και άλλα συμπτώματα. Άλλα συμπτώματα μπορεί να περιλαμβάνουν:
- Κεφαλαλγία
- Πόνο στο στομάχι
- Ναυτία ή έμετο
- Εξάνθημα (οστρακιά)
Τα συμπτώματα δεν περιλαμβάνουν βήχα ή καταρροή. Τα ακόλουθα συμπτώματα υποδηλώνουν ότι ο ιός είναι η αιτία της ασθένειας αντί για τον στρεπτόκοκκο:
- Βήχας
- Καταρροή
Βραχνή φωνή - Επιπεφυκίτιδα (ροζ μάτι)
Μερικοί άνθρωποι διατρέχουν αυξημένο κίνδυνο
Οποιοσδήποτε μπορεί να νοσήσει από στρεπτόκοκκο στο λαιμό, αλλά υπάρχουν ορισμένοι παράγοντες που μπορούν να αυξήσουν τον κίνδυνο εμφάνισης αυτής της κοινής λοίμωξης.
Ηλικία
Ο στρεπτόκοκκος στο λαιμό είναι πιο συχνός στα παιδιά παρά στους ενήλικες και συγκεκριμένα σε παιδιά ηλικίας 5 έως 15 ετών, ενώ είναι πολύ σπάνιος σε παιδιά μικρότερα των 3 ετών.
Κοντινή απόσταση
Η στενή επαφή με άλλο άτομο που νοσεί από στρεπτόκοκκο είναι ο πιο κοινός παράγοντας κινδύνου για μετάδοση. Για παράδειγμα, εάν κάποιος έχει στρεπτόκοκκο ομάδας Α, τα βακτήρια εξαπλώνονται συχνά σε άλλα άτομα του νοικοκυριού τους.
Επαφή με παιδιά: Οι γονείς των παιδιών σχολικής ηλικίας και οι ενήλικες που έρχονται συχνά σε επαφή με παιδιά διατρέχουν αυξημένο κίνδυνο.
Οι δομές μπορούν να αυξήσουν τον κίνδυνο μόλυνσης από στρεπτόκοκκο. Αυτές οι δομές περιλαμβάνουν:
- Παιδικούς σταθμούς και σχολεία
- Καταστήματα κράτησης ή σωφρονιστικών ιδρυμάτων
- Καταφύγια αστέγων
- Στρατιωτικές εγκαταστάσεις εκπαίδευσης
Ένα απλό τεστ δίνει γρήγορα αποτελέσματα
Ο γιατρός (Παιδίατρος, Παθολόγος) μπορεί να κάνει τη διάγνωση, ανάλογα με τα συμπτώματα και τη φυσική εξέταση. Εάν υπάρχει υπόνοια στρεπτόκοκκου ομάδας Α, θα πρέπει να πραγματοποιηθεί το αντίστοιχο τεστ. Υπάρχουν δύο τύποι τεστ για το στρεπτόκοκκο ομάδας Α: ένα γρήγορο τεστ στρεπτόκοκκου και η καλλιέργεια επιχρίσματος στο λαιμό.
Γρήγορο τεστ στρεπτόκοκκου (Strep Test)
Ένα γρήγορο τεστ στρεπτόκοκκου περιλαμβάνει υλικό από φαρυγγικό επίχρισμα. Η εξέταση μπορεί να απαντήσει γρήγορα στο αν η ασθένεια προκαλείται από βακτήρια στρεπτόκοκκου ομάδας Α.
Καλλιέργεια φαρυγγικού επιχρίσματος
Η καλλιέργεια χρειάζεται χρόνο για να απαντήσει εάν τα βακτήρια του στρεπτόκοκκου της ομάδας Α αναπτύσσονται από το στυλεό. Αν και χρειάζεται περισσότερος χρόνος, η καλλιέργεια φαρυγγικού επιχρίσματος εντοπίζει μερικές φορές λοιμώξεις που μπορεί να μην ανιχνευτούν από το γρήγορο τεστ στρεπτόκοκκου.
Ποιες είναι οι οδηγίες στην περίπτωση που το τεστ βγει θετικό
Η νόσηση από στρεπτόκοκκο ομάδας αντιμετωπίζεται με αντιβιοτικά. Επίσης, είναι σημαντικό να καλέσουμε τον γιατρό εάν εμείς ή το παιδί μας δεν αισθάνεται καλύτερα μετά τη λήψη αντιβιοτικών για 48 ώρες. Επιπλέον συστήνεται η παραμονή στο σπίτι και η αποφυγή επίσκεψης κοινόχρηστων χώρων, όπως το μέρος εργασίας, το σχολείο, ο παιδικός σταθμός μέχρι ο πυρετός να υφεθεί. Συστήνεται η λήψη αντιβιοτικών. Ο γιατρός μπορεί να αποφανθεί για το πόσες ημέρες μπορεί να παραμείνει ο ασθενής σπίτι.
Φορείς στρεπτόκοκκου
Φορέας καλείται το άτομο που βγαίνει θετικό αλλά δεν έχει συμπτώματα. Σε αυτήν την περίπτωση δεν συστήνονται αντιβιοτικά. Για τους φορείς είναι ελάχιστα πιθανό να μεταδώσουν τη λοίμωξη σε άλλους και πολύ απίθανο να παρουσιάσουν επιπλοκές.
Εάν ένας φορέας εμφανίσει ιογενή πονόλαιμο (με ή χωρίς εξάνθημα), ένα τεστ στρεπτόκοκκου μπορεί να είναι θετικό. Σε αυτές τις περιπτώσεις, είναι δύσκολο να διευκρινιστεί τι προκαλεί τον πονόλαιμο. Εάν υπάρχουν ενδείξεις ότι είμαστε φορείς στρεπτόκοκκου εμείς ή τα παιδιά μας θα πρέπει και πάλι να απευθυνθούμε στον παθολόγο ή τον παιδίατρό μας.
Ποιες είναι οι οδηγίες στην περίπτωση που το τεστ βγει αρνητικό
Μετά από ένα αρνητικό γρήγορο τεστ στρεπτόκοκκου, ο γιατρός μπορεί να συστήσει επίσης μια καλλιέργεια φαρυγγικού επιχρίσματος.
Ενώ για τα παιδιά και τους εφήβους η καλλιέργεια είναι σημαντικό να διεξαχθεί, για τους ενήλικες συνήθως δεν προτείνεται. Τα αντιβιοτικά δεν χρειάζονται εάν όλα τα αποτελέσματα των εξετάσεων είναι αρνητικά.
Τα αντιβιοτικά χρησιμοποιούνται για θεραπεία
Οι γιατροί συνταγογραφούν τα αντιβιοτικά στην περίπτωση του στρεπτόκοκκου ομάδας Α για τη:
- Μείωση του χρόνου νόσησης
- Μείωση συμπτωμάτων
- Αποφυγή εξάπλωσης
- Αποφυγή σοβαρών επιπλοκών όπως ο ρευματικός πυρετός
Οι σοβαρές επιπλοκές δεν είναι συχνές
Επιπλοκές μπορεί να εμφανιστούν μετά από λοίμωξη από στρεπτόκοκκο ομάδας Α, εάν τα βακτήρια εξαπλωθούν σε άλλα μέρη του σώματος. Οι επιπλοκές μπορεί να περιλαμβάνουν:
- Αποστήματα (πύον) γύρω από τις αμυγδαλές ή στο λαιμό
- Ιγμορίτιδα
- Μολύνσεις αυτιών
- Ρευματικός πυρετός (μια ασθένεια που μπορεί να επηρεάσει την καρδιά, τις αρθρώσεις, τον εγκέφαλο και το δέρμα)
- Μεταστρεπτοκοκκική σπειραματονεφρίτιδα (νεφρική νόσος)
Προστατέψτε τον εαυτό σας και τους άλλους
Οι άνθρωποι μπορεί να νοσήσουν από στρεπτόκοκκο περισσότερες από μία φορές. Αν και δεν υπάρχει εμβόλιο για την πρόληψη του στρεπτόκοκκου, υπάρχουν οδηγίες που μπορούν να ακολουθήσουν οι άνθρωποι για να προστατεύσουν τον εαυτό τους και τους γύρω τους.
Υγιεινές συνήθειες
Πολλές καθημερινές υγιεινές συνήθειες μπορούν να βοηθήσουν στην πρόληψη λοιμώξεων:
- Καλύψτε το στόμα και τη μύτη σας με χαρτομάντιλο όταν βήχετε ή φτερνίζεστε.
- Βάλτε το χρησιμοποιημένο χαρτομάντιλο στο καλάθι απορριμμάτων.
- Βήχετε ή φτερνίζεστε στο επάνω μανίκι ή στον αγκώνα σας, όχι στα χέρια σας, εάν δεν έχετε χαρτομάντιλο.
- Πλένετε συχνά τα χέρια σας με σαπούνι και νερό για τουλάχιστον 20 δευτερόλεπτα.
- Χρησιμοποιήστε ένα αντισηπτικό εάν δεν υπάρχουν διαθέσιμα σαπούνι και νερό.
- Πλένετε τα ποτήρια, τα σκεύη και τα πιάτα αφού τα χρησιμοποιήσει κάποιος που είναι άρρωστος. Αυτά τα αντικείμενα είναι ασφαλή για χρήση από άλλους αφού πλυθούν.
Το διαβάσαμε εδώ oloygeia.gr